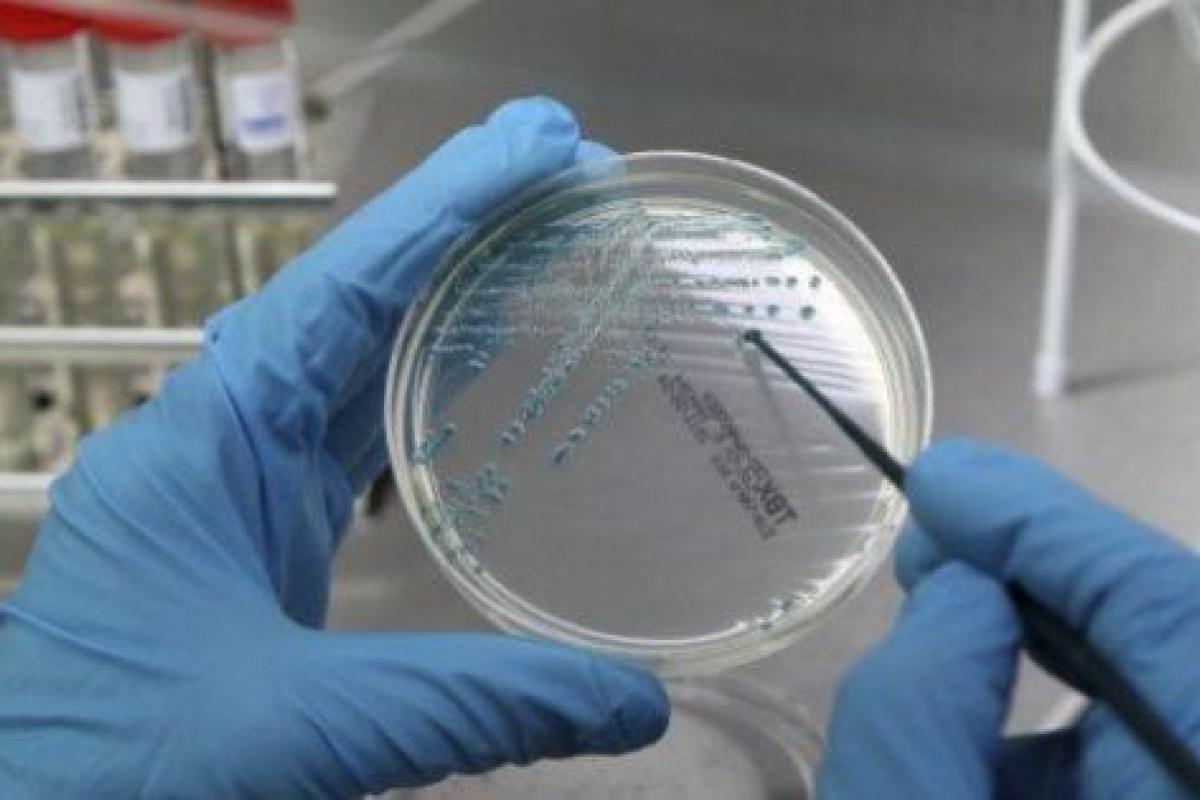

Un fármaco consigue mejorar un 38% la supervivencia en pacientes con cáncer de hígado
Un ensayo realizado en 152 hospitales de 21 países con 573 pacientes y coordinado por el jefe de la Unidad de Oncología Hepática del Hospital Clínic-Idibaps, Jordi Bruix, ha demostrado que un fármaco mejora un 38 % la supervivencia en pacientes con cáncer de hígado cuando otras alternativas fallan.
El resultado de la investigación, que publica hoy la revista "The Lancet", ha demostrado que el Regorafenib mejora la supervivencia de pacientes con carcinoma hepatocelular (HCC) cuando la enfermedad progresa y no hay otras alternativas terapéuticas.
Según ha señalado Bruix, éste es el único fármaco que ha mostrado resultados positivos para este tipo de cáncer en los últimos diez años.
LA FORMA MÁS COMÚN
Bruix, que también es director científico del Centro de Investigación Biomédica en Red de Enfermedades Hepáticas y Digestivas (CIBEREHD), ha explicado que el carcinoma hepatocelular es la forma más común de cáncer de hígado y representa entre el 70-85 % de los tumores hepáticos malignos.
Se trata del sexto tipo de cáncer más frecuente en el mundo, se diagnostican 780.000 nuevos casos cada año y es la tercera causa de muerte por cáncer.
El oncólogo ha indicado que en la actualidad sólo hay una opción de tratamiento sistémico aprobado para pacientes con HCC, Sorafenib, pero cuando este fármaco falla y la enfermedad progresa no hay opciones de tratamiento de segunda línea de eficacia probada para los pacientes con esta enfermedad.
En el estudio, a los 573 pacientes con carcinoma hepatocelular los dividieron aleatoriamente en dos grupos: 379 fueron tratados con Regorafenib, además del mejor tratamiento de apoyo disponible, y 194 recibieron placebo, además del mismo tratamiento de apoyo.
RETRASO EN LA PROGRESIÓN
Los resultados han demostrado que el tratamiento retrasa la progresión del cáncer, con una reducción del 38% del riesgo de muerte durante el período del estudio.
Además, según Bruix, se trata de un fármaco seguro y bien tolerado por los pacientes (sólo un 10% de los pacientes tuvieron que abandonar el estudio debido a la toxicidad del tratamiento).
"En los diez últimos años ningún otro fármaco ha superado a Sorafenib como tratamiento de primera línea y ningún otro ha obtenido resultados positivos como terapia de segunda línea frente a placebo.
Por tanto, los resultados observados con Regorafenib representan un avance muy relevante para los pacientes y ofrecen una opción terapéutica adicional", ha resumido Bruix.
"El futuro del tratamiento de este tipo de cáncer es la combinación de diferentes fármacos o la combinación con moduladores de la inmunidad", ha agregado el oncólogo.





